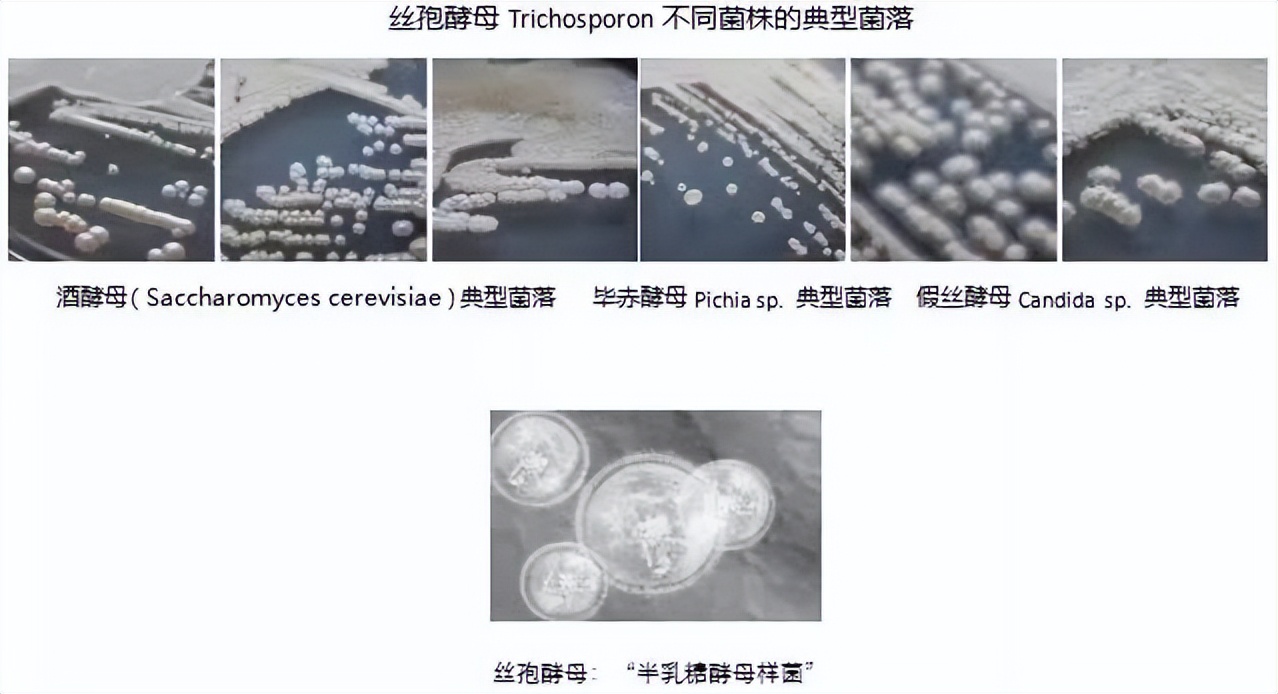
你真的会用爽肤水这些误区要避开,爽肤水到底是鸡肋还是护肤必备

冬天到了,糖精们还会 每天使用爽肤水 吗?
作为入门级的产品, 爽肤水是不少人护肤的启蒙单品 ,在护肤流程中的地位甚至不亚于现在的精华液。市场上也曾出现过粉水、神仙水、健康水......等众多网红爆款。
但是近些年来,大家对爽肤水的态度却开始变了:

随着对产品功效的在意,爽肤水的地位直线下降。甚至出现了“爽肤水不是必须要的”“贵价爽肤水是智商税”等声音。
那水类产品作用大吗?到底要不要用?不同肤质又该怎么选?今天我们就来聊一聊。

01
这个“水”还真有必要!
作为护肤的成分宇宙里,最常见的基础成分, 水并非无用 。使用清水、化妆水、精华水甚至用洗面奶洗完脸后,即刻的感觉都还是比较水润的(也就是我们常常理解的补水)。

这是因为我们角质层能够吸收一点点水,从而在短时间内使皮肤含水量增加。
但这一点点水比较容易蒸发且不能维持,透皮失水率(TEWL)也会增加。
所以单纯用水来保湿的确是即时效果,不能持久。所以我们常说,需要在使用纯水喷雾对肌肤进行浸润之后,尽可能快点做好带有一定封闭性的保湿。

不过皮肤含水量增加,也会后续护肤带来一些好处,角质层会变得更加柔润平滑,后续使用相对滋润厚重的产品时,呈现的肤感会更加舒适, 爽肤水在这时候就起到了一个“优化肤感”的作用。
此外,我们知道活性物的真正吸收需要时间,以及配合配方工程师聪明的各类促渗手段。
而使用 爽肤水使皮肤含水量增加之后 ,皮肤的渗透性增强,这时外界的物质会更容易通过含水量比较高的皮肤,所以 后续的护肤会更容易被皮肤吸收 。

既能优化肤感”又能促进“吸收”,那为什么还有人说没必要使用爽肤水呢?
资深护肤专家@冰寒老师曾回答过这个问题,他的观点是: 水类产品可以用也可以不用,完全视你皮肤的需要。
如果你有精华类的产品,它既可以起到“补水”(浸润)和调节pH值,又能够达到调节保护护肤的作用,这时可以不使用水类产品的;如果你觉得精华太粘稠,霜、乳液太油腻,那么只使用一款水也就足够了。


总结下来就是, 水类产品的用或不用,取决于自己的感受和实际需要 。我们一直强调,护肤没有什么规矩、流程,只要遵循温和不伤害肌肤,使用正规的产品,就是合理的。
或者如果你有其它清爽、流动性强的产品、可以起到浸润角质的产品, 爽肤水也是可以不用的。


比如,以肌底液自居,甚至带动半个市场开始宣称“肌底液”的兰蔻全新精华肌底液(小黑瓶),类似的产品还有碧欧泉护肤精粹液、上水和肌屏障修护肌底液、至本特安修护肌底液等。
总的来说, 爽肤水、清爽的 (肌底) 精华产品,还是值得去使用的 。尤其是在干燥的秋冬季节,不仅能帮助肌肤保持水润、也有助于后续功效产品更好地发挥作用。

当然,如果想精简护肤、减少使用的产品,也可以 趁洗完脸 ,脸部的肌肤比较湿润柔嫩的几分钟, 赶紧去护肤,做好保湿。
02
贵价爽肤水就是智商税?
通常,很多小伙伴会觉得,爽肤水产品不值得买贵的,因为它只是个爽肤水。 这个观点对,也不完全对 。
护肤水的剂型,确实限制了很多脂溶性活性物的添加,但是这不妨碍市面上存在大批经久不衰的贵价爽肤水产品。


举个例子, SK-II® 护肤精华露 ,大名鼎鼎的神仙水,可以说就是一瓶 半乳糖酵母样菌发酵产物滤液 ,依靠这个富有传奇色彩的发酵产物,在护肤品界的地位无可撼动。
这几年,神仙水里的 半乳糖酵母样菌发酵产物滤液 ,被科学家们研究得越来越透彻,也进一步证实了它的 可靠护肤作用 。
同样拿发酵产物打天下的雅娘娘怎么能忍,作为一手捧红二裂酵母发酵产物溶胞产物的品牌,推出了雅诗兰黛微精华露、雅诗兰黛樱花版微精华露来抗衡发酵产物精华水的市场。


除了二裂酵母发酵产物溶胞产物,雅诗兰黛的微精华里还运用了 乳酸杆菌发酵产物 ,配合集团上山使用的乙酰壳糖胺、海藻糖、糖海带提取物等, 在抗老平滑、紧致提亮等方面,都有亮眼的效果。
两款发酵产物的精华水, 活性物配合都非常到位 ,前者极简的像个原料桶,后者具有典型的“鸡尾酒配方“风格,都是优秀的产品。
03
不同肤质如何挑选适合自己的爽肤水?
爽肤水的选择上,其实还是比较有技巧的,我们一起来梳理思维。
对于干皮来说 ,爽肤水除了要能提供浸润效果,也需要它能具有良好的保湿效果。


当下火热的水溶性成分 依克多因 (四氢甲基嘧啶羧酸), 就非常适合干皮来使用。 依克多因因为它极强的与水分子结合的作用,在这几年的舒缓修护产品中大放异彩。
因为 它能帮助肌肤抓住更多水,更多更多,超多超多超多的水分子。 这些水分子保护细胞里面的各种蛋白质和DNA,相当于形成肉眼不可见的了“水魔法阵”。

使得它在光保护,下调肌肤炎症因子, 对抗污染物等方方面面都能露一手 。也使得依克多因,这个看似平平无奇的化学物质,拥有了生物活性。
其实,样的成分不在少数, 还有我们熟悉的乳糖酸 (以及不同的多羟基酸), 也是因为强大的抓水作用 ,被我们称作“生物酸”;还有我们熟悉的 糖类物质 ,比如玻色因、鼠李糖、甘露糖、海藻糖、甚至蔗糖;当然, 甘油 也是这样。
所以,肌肤偏干的小伙伴,知道冬天选择含有什么成分的爽肤水了吗?
干皮爽肤水推荐

▲从左到右:est嫒色透润保湿化妆水、MONSTER CODE 四二舒润精华喷雾、米蓓尔新多元修护润养水、雅诗兰黛微精华露
对于油性肌肤来说 ,值得考虑的爽肤水成分,比如上面提到的 乳酸杆菌发酵产物 ,作为一种发酵产物,平衡肌肤微生态,强韧维稳自然不在话下。
来自德之馨的乳酸杆菌发酵产物商品名叫做 SymReboot™ L19 ,对乳酸杆菌进行加工,让它在护肤运用中模拟活菌的作用, 调节抗菌肽的表达,舒缓皮肤、增强皮肤屏障;


华熙生物推出的乳酸杆菌发酵产物叫做 Biobloom™微美态ME-2 ,在维持面部微生态的同时有不错的抗氧化作用,用于 减轻肌肤损伤 。
整体上,发酵产物对于出油多,容易长痘痘的小伙伴来说非常有益。
油皮爽肤水推荐

▲从左到右:SK-II® 护肤精华露、朗仕锋范抗皱紧致精华水、羽西虫草焕颜新肌调理液、至本多元优效精粹水

其实,无论是保湿水、柔肤水、精华水等等水类的产品,它们都衍生自最初的爽肤水,都 具备最为基础的浸润角质的功能 。
有些一爽肤水,添加适当的活性物,能够起到更强的抓水保湿,滋润修护的功效。


不过身处冬季的我们,一定要在使用爽肤水、清爽的精华产品之后,尽快使用具有一定赋脂、封闭效果的产品,让角质层更久得保持润润的状态。 毕竟保湿就是为修护、美白、抗老夯实基础。
以上的产品全是抛砖引玉,希望大家能够在自己的护肤流程中,实践运用起来,让肌肤水水嫩嫩。
策划:Cindy 监制:Phyllis
排版:熊仔
审稿:言安堂研究院
本文由言安堂内容团队原创,部分图片来自网络
支持原创,抄袭可耻,转载请联系